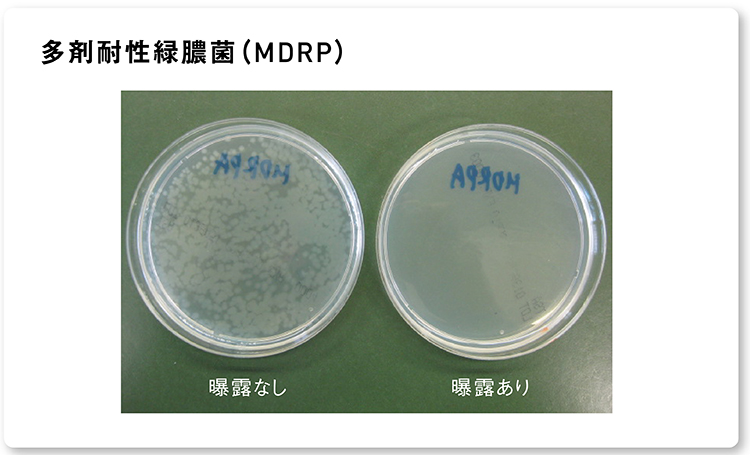
画像：ナノイー（帯電微粒子水）を2時間曝露した後の多剤耐性緑膿菌（MDRP）の生菌数現象の様子
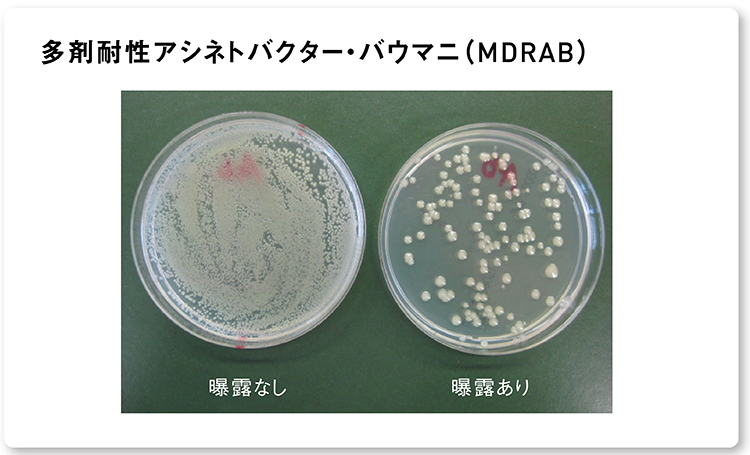
画像：ナノイー（帯電微粒子水）を2時間曝露した後の多剤耐性アシネトバクター・バウマニ（MDRAB）の 生菌数減少の様子

多くの抗菌薬(抗生物質)に耐性を獲得する多剤耐性菌2種について、菌数を99%以上抑制する効果を確認!試験の結果、ナノイー(帯電微粒子水)を2時間照射することで多剤耐性菌2種を99%以上抑制※することが確認出来ました。
※試験は45Lの試験空間で実施され、実使用における製品の効果を実証したものではありません。
「背景」
19世紀末から20世紀の初めにかけて病原細菌が次々と発見され、それに伴い抗菌薬(抗生剤)の開発が盛んになりました。その一方で、抗菌薬の使用により細菌が変異し耐性化。多くの抗菌薬に対して耐性を示す多剤耐性菌が出現しました。
多剤耐性菌とは
複数の抗菌薬に耐性(抵抗性)を示す病原細菌で、使用できる抗菌薬が限られるため治療が困難となります。今回は、感染症の治療薬であるほぼ全ての抗菌薬の効果が期待できない多剤耐性緑膿菌(MDRP)と、病院の水回りなどに存在することが多い多剤耐性アシネトバクター・バウマニ(MDRAB)に対する抑制効果を検証しました。
「検証結果」
ナノイー(帯電微粒子水)の曝露で多剤耐性菌2種を99%以上抑制
多剤耐性緑膿菌(MDRP)、多剤耐性アシネトバクター・バウマニ(MDRAB)に対し、ナノイー(帯電微粒子水)を2時間曝露することで菌数を99%以上抑制しました。
ナノイー(帯電微粒子水)を2時間曝露した後の
多剤耐性緑膿菌(MDRP)の抑制率
ナノイー(帯電微粒子水)を2時間曝露した後の
多剤耐性緑膿菌(MDRP)の生菌数現象の様子
ナノイー(帯電微粒子水)を2時間曝露した後の
多剤耐性アシネトバクター・バウマニ(MDRAB)の抑制率
ナノイー(帯電微粒子水)を2時間曝露した後の
多剤耐性アシネトバクター・バウマニ(MDRAB)の生菌数減少の様子
[プレスリリース]
帯電微粒子水「nanoe(ナノイー)(※1)」による多剤耐性菌の抑制効果を検証(2010年11月17日)
https://www.panasonic.com/content/dam/panasonic/jp/corporate/technology-design/nanoe/pdf_20101117_nanoe.pdf